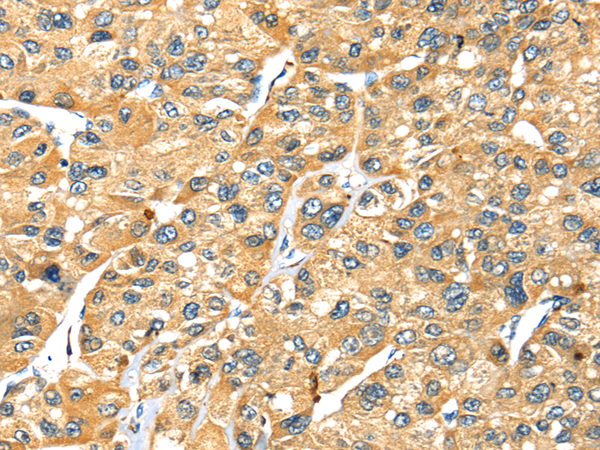
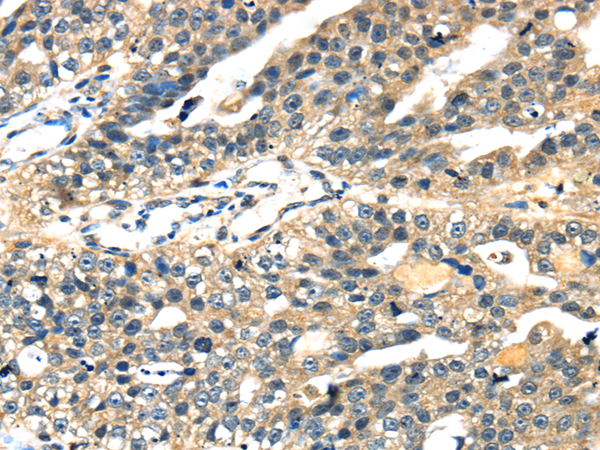

-
分类: 科研抗体货号: P08827别名: CARB应用: WB,IHC反应种属: Human, Mouse, Rat
-
分类: 科研抗体货号: P08839别名: HDL4; GTF2D; SCA17; TFIID; GTF2D1应用: WB,IHC反应种属: Human
-
分类: 科研抗体货号: P08819别名: ST1B1; ST1B2; SULT1B2应用: WB,IHC反应种属: Human
-
分类: 科研抗体货号: P08826别名:应用: IHC反应种属: Human, Mouse, Rat
-
分类: 科研抗体货号: P08838别名: ABC7; ASAT; Atm1p; EST140535应用: IHC反应种属: Human, Mouse, Rat
-
分类: 科研抗体货号: P08818别名: P67; NSEC1; UNC18; RBSEC1; MUNC18-1应用: WB,IHC反应种属: Human, Mouse, Rat
-
分类: 科研抗体货号: P08856别名: MTRX; TRX2; MT-TRX应用: IHC反应种属: Human, Mouse, Rat
-
分类: 科研抗体货号: P08836别名: TAF2J; TAFII20应用: IHC反应种属: Human, Mouse
-
分类: 科研抗体货号: P08817别名: KRCT; MPSK; TSF1; PKL12应用: WB,IHC反应种属: Human, Mouse, Rat
-
分类: 科研抗体货号: P08855别名:应用: IHC反应种属: Human

鄂公网安备42018502007531号
鄂公网安备42018502007531号

